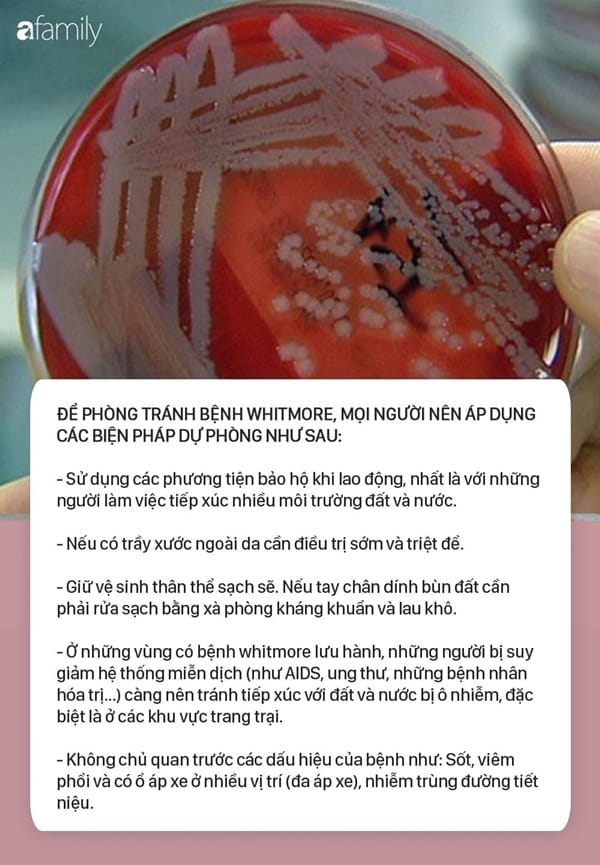

Hơn 100 doanh nghiệp tại Việt Nam cùng nhau cam kết đạt 100 ngày không xảy ra tai nạn lao động tại..
Tin tức an toàn

100 nhà máy 'nói không' với tai nạn lao động nơi sản xuất

Tạo chuyển biến trong công tác an toàn vệ sinh lao động, phòng chống cháy nổ
Hưởng ứng Tháng hành động về an toàn, vệ sinh lao động (ATVSLĐ) năm 2019, Hội đồng ATVSLĐ tỉnh...

Bị cuốn vào máy kéo sợi, một công nhân tử vong
Tai nạn lao động luôn là nỗ đau đớn dai dẳng bởi hậu quả mà nó để lại không chỉ là vết thương...

Đánh giá hiệu quả thực hiện an toàn, vệ sinh lao động tại các doanh nghiệp hiện nay
Hiện nay, theo thống kê thì trên cả nước có khoảng 890.000 doanh nghiệp đăng ký hoạt động

600 doanh nghiệp xây dựng hệ thống quản lý an toàn, vệ sinh lao động
Bộ LĐ-TB&XH đề cao những giải pháp gắn kết với doanh nghiệp để giúp người lao động nâng cao hiệu quả
⚠️ CĂN BỆNH BỊ LÃNG QUÊN QUAY TRỞ LẠI⚠️
Whitmore không phải bệnh mới và hiếm gặp mà bị "bỏ quên" trong cộng đồng

Phòng ngừa tai nạn lao động và bệnh nghề nghiệp: Nhận thức tăng lên, rủi ro sẽ giảm
công tác tuyên truyền hay thanh tra, kiểm tra chỉ là những giải pháp tình thế!